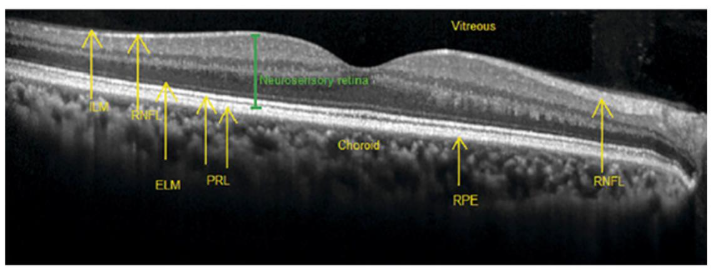
An OCT scan of a normal retina

OCT Testing

OCT testing, or to give it its long name, Optical Coherence Tomography, is available at Penzer Opticians for NHS, private patients and non registered patients too.
For many years OCT testing was used in eye hospitals and for research purposes only. But now this state-of-the-art eye technology is available in independent opticians; and Penzer Opticians has invested in the super fast REVO OCT eye scanner.
OCT testing is not part of the NHS Eye Test but is performed as part of an extended eye test at an extra cost.
Optical Coherence Tomography utilises complex technology used to create images of the eye and, in particular, the layers of the retina. An OCT scan uses light to take over one thousand images of the back of your eye and beyond. The retina is the light sensitive area at the back of the eye, equivalent to film in a camera or CCD in a digital camera.
In layman’s terms, OCT is a non-invasive imaging technique that uses light waves to create detailed images of the back of your eye, including the retina and macula. It works similarly to an ultrasound but uses light instead of sound waves, allowing for a 3D view of the eye’s layers. Retinal pathology can be detected with OCT by observing changes in retinal thickness and changes in reflectivity of the various structures. It is particularly useful for detecting early signs of glaucoma and macular degeneration, as these subtle retinal changes may not be visible during standard eye exams. With an OCT scan, what is happening in the retina, can be visualised much earlier than normal ophthalmoscopy. This can lead to an earlier diagnosis and referral.
Does the scan hurt?
OCT testing is simple and non-invasive, taking only a few minutes to complete. There are no flashing lights or other nasty surprises! The imaging test uses light waves to take cross-section pictures of your retina, the light-sensitive tissue lining the back of the eye.
You will be seated by one of the Penzer optical receptionists in front of the Optical Coherence Tomography machine and will rest your head on a support to keep it still. The equipment will then scan your eye without touching it. Scanning takes juts a moment or two. If your eyes were dilated for the test, they may be sensitive to light for several hours after the exam.
Now watch the video below to see in more detail how it all works.
What does the optician see from OCT testing?
By using the Optical Coherence Tomography machine the optician is instantly given the results of your scan so he/she can pick up any earlier signs of deterioration in your eyes. This means treatment options can be assessed and implemented before the problem becomes serious.
In addition, OCT testing is often used to evaluate disorders of the optic nerve. The optic nerve is made up of many nerve fibres and sends signals from the retina to the brain. These signals are interpreted as the images you see. OCT testing is helpful in determining changes to the fibres of the optic nerve, such as those caused by glaucoma.
OCT testing is not provided by the NHS on a free basis. You will need to book an appointment for this special test, for which there is a charge of just £39.
It is important to know just how healthy your eyes are and OCT testing will reveal their state in detail. So if you value the care of your eyes, act now by booking an appointment with Penzer Opticians on 0121 430 5538.
